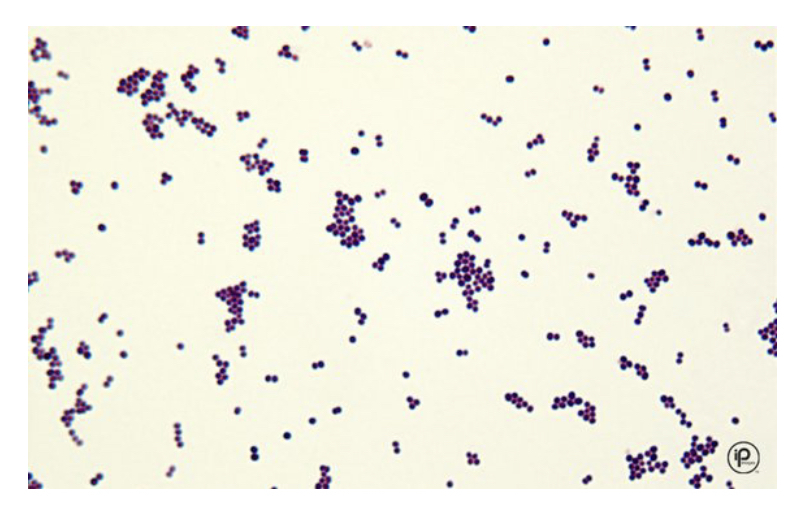

How do bacteria tend to be classified?
By their Gram stain and then their shape
e.g. Gram negative bacillus
What is the difference in cell structure between a Gram + and Gram - bacterial cell?
Gram positive:
- thick cell wall that retains Gram stain
- more resistant to drying so is often found on the skin
Gram negative:
- thinner cell wall that does not retain gram stain
- they have a fatty outer cell membrane made from lipopolysaccharides
- requires moisture to survive
- often found in the large bowel and moist areas of the skin

What is the difference between a coccus and a bacillus?
Cocci are more circular in shape
Bacilli are rod-shaped

What are the 3 intervening factors that explain why certain bacteria cause particular infections?

Host factors:
- devices
- immune system
Opportunity:
- normal flora
- exposure
Bacterial factors:
- virulence
- resistance
- environmental survival

What is meant by “devices” as a host factor determining why bacteria cause particular infections?
Devices act as a portal of entry for infection
e.g. Catheters and lines when in hospital
What is meant by “immune system” as a host factor?
infections are more common in immunocompromised patients
e.g. Leukaemia, patients on immunosuppressants after transplants
What is meant by “virulence” as a bacterial factor?
Virulence factors are different in all bacteria
they allow for enzyme production, breakdown of tissues and evasion of host immune defences
Depending on the bacterium, they wil have particular virulence factors which may make them more able to cause infection
What is meant by “environmental survival” as a bacterial factor?
some bacteria are more resistant to environmental stresses
e.g. Drying out, formation of biofilms allows them to adhere to things such as plastic
How are “normal flora” involved in opportunity?
the proximity of the normal flora to the site of infection has an influence
e.g. Anal bacteria getting into a place that they shouldn’t after colonoscopy
What is the most common bacteria to cause UTIs?
In which group is this more prevalent and why?
E. Coli
Females are more prone to UTIs as they have a shorter urethra
This is a shorter distance for the bacteria to ascend
Which areas are colonised in a UTI caused by E. Coli?
they colonise the urethral meatus and the surrounding area
they are able to adhere to uroepithelal cells and urinary catheter materials
What is significant about UTI by E. Coli?
How do they cause symptoms?
They trigger the host inflammatory response, leading to pain and dysuria
They are able to develop resistance to antibiotics
What is the most common bacterium to cause skin infections?
Where is it usually found?
Stapyloccoccus aureus
It is found in the nasal carriage of 50% of healthy people
It is able to adhere to damaged skin (e.g. burns, skin conditions, abrasion)
What is the mechanism of action behind an S. aureus skin infection?
it produces exoenzymes and toxins that can damage tissues
this provokes the host inflammatory response
e.g. pus formation
What is meant by Staphylococcus aureus being a primary pathogen?
it can cause infection in normal healthy people
(not immunocompromised)
What types of infection tend to be caused by Staphylococcus aureus?
how is this organism classified?
Gram positive coccus
It causes skin and soft tissue infections, including surgical site infections
In severe cases it can cause bacteriaemia and septicaemia
What are less common conditions caused by Staphylococcus aureus?
- osteomyelitis
- septic arthritis
even less common:
- endocarditis
- pneumonia
- UTI
- meningitis
What is meant by bacteraemia?
Bacteriaemia is the presence of bacteria within the blood stream
What does Staphylococcus aureus look like under the microscope?
Gram positive coccus
”Staphylo” means bunch of grapes
What type of bacteria is staphylococcus epidermidis?
Where does it tend to be found?
Coagulate negative staphylococci
it is an opportunistic pathogen and is carried on the skin of most people
How does staphylococcus epidermidis tend to cause infection?
It causes infection in association with foreign bodies (e.g. catheters, prosthetic joints)
it adheres to plastics/metals using glycocalyx, forming biofilms
(this is in the period where the prosthetic joint is exposed to air, before surgical insertion)
this leads to loosening of the prosthetic joint and instability and pain in the joint
What is an alternative name for Streptococcus pyogenes?
What is it the commonest cause of?
Group A Strep
It is a Gram positive coccus
It is the commonest cause of bacterial sore throat
What other conditions are caused by streptococcus pyogenes?
- Scarlet fever
- Necrotising fasciitis
- Invasive infections, such as pneumonia
- Puerperal sepsis
- Secondary immunological presentations, such as glomerulonephritis
What is a typical feature of scarlet fever?
“Strawberry tongue”







